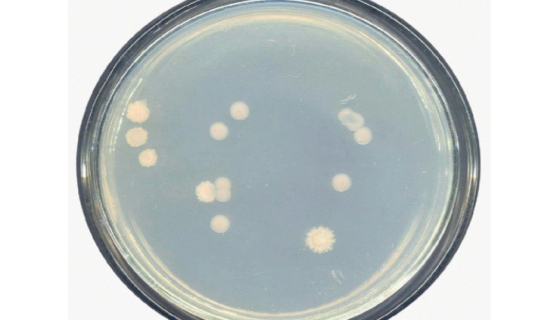
产氮假单胞菌的培养方法与实验内容及使用范围！

NCI-H660人神经内分泌前列腺癌细胞的培养步骤!
人神经内分泌前列腺癌细胞的运输和保存及培养步骤。

ATCC 27479 绿孢链霉菌的保存方法与实验内容!
绿孢链霉菌,放线菌生物,甘油天冬素琼脂(ISP)、无机盐淀粉...

人雪旺细胞永生化的使用方法与培养操作步骤!
雪旺细胞沿神经元的突起分布,包裹在神经纤维上,雪旺细胞的外表...

紫麦角菌的形态特征与打管说明及注意事项!
紫麦角菌,真菌门、麦角菌科中的一属。分布广泛、是禾本科植物的...

大鼠视网膜前体细胞的复苏与传代及冻存操作说明!
大鼠视网膜前体细胞分离自视网膜组织;视网膜居于眼球壁的内层,...

WISH(人羊膜细胞)的处理方法与培养步骤!
人羊膜细胞收到后的处理方法与培养操作步骤有哪些?
产氮假单胞菌的培养方法与实验内容及使用范围!
产氮假单胞菌是Pseudomonas属的微生物,原产地为中国...

肠沙门氏菌肠炎亚种的培养方法与注意事项!
肠沙门氏菌肠亚种是Salmonella属的微生物,原产地为中...

MOC2小鼠口腔鳞状细胞癌细胞的培养操作步骤!
小鼠口腔鳞状细胞癌细胞的复苏与传代及冻存操作说明。